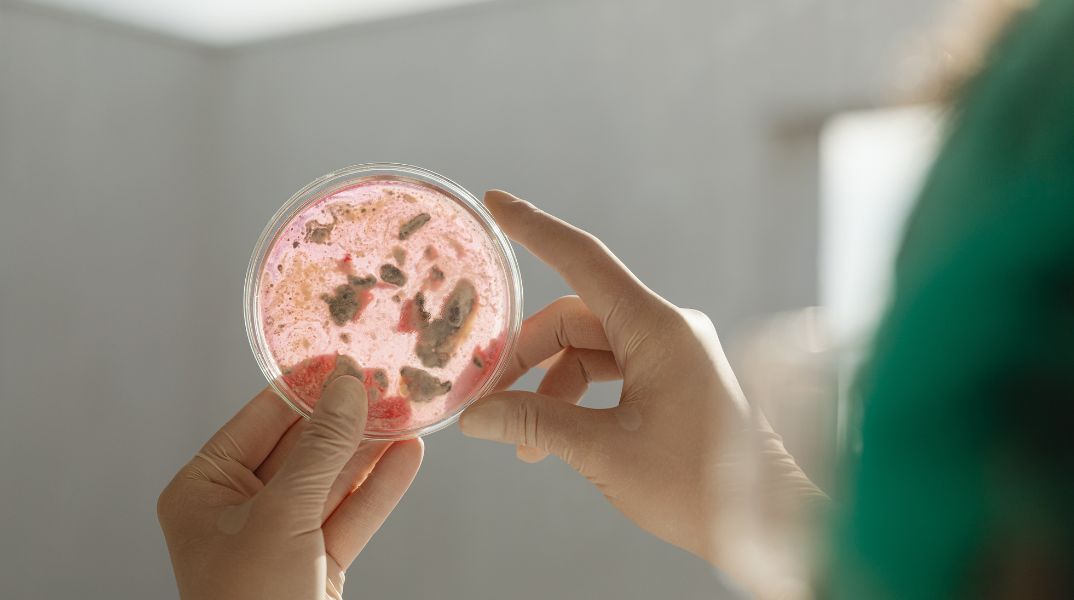
Ανασκόπηση Nature: Δέκα άνθρωποι που βοήθησαν στη διαμόρφωση της επιστήμης το 2023 - Ανάμεσά τους μια Ελληνίδα - Οι πρωτοποριακές ανακαλύψεις της χρονιάς.

- CITY GUIDE
- PODCAST
-
 17°
17°
10 άνθρωποι που καθόρισαν τις επιστήμες το 2023 - Η λίστα του Nature
Εκπληκτικές ανακαλύψεις και κρίσιμα ζητήματα της χρονιάς που φεύγει

Ανασκόπηση Nature: Δέκα άνθρωποι που βοήθησαν στη διαμόρφωση της επιστήμης το 2023 - Ανάμεσά τους μια Ελληνίδα - Οι πρωτοποριακές ανακαλύψεις της χρονιάς.
Ένας πρωτοπόρος της τεχνητής νοημοσύνης, ένας αρχιτέκτονας της αποστολής της Ινδίας στη Σελήνη και ο πρώτος παγκόσμιος αξιωματικός θερμότητας στον κόσμο είναι μερικοί από τους ανθρώπους πίσω από τις μεγάλες επιστημονικές ιστορίες της φετινής χρονιάς.
Η λίστα των 10 κορυφαίων του Nature διερευνά τις βασικές εξελίξεις στην επιστήμη τον περασμένο χρόνο και μερικά από τα άτομα που βοήθησαν να γίνουν εκπληκτικές ανακαλύψεις και να επιστήσουν την προσοχή σε κρίσιμα ζητήματα.
Όπως επισημαίνει το Μέσο, δεν είναι ένα βραβείο ή μια αξιολογική κατάταξη, αλλά μια επιλογή που συντάχθηκε από τους αρθρογράφους του Nature για να αναδείξει τις πιο συναρπαστικές επιστημονικές ιστορίες της χρονιάς.
Από την έναρξή του πριν από περισσότερο από μια δεκαετία, το «Nature’s 10» έχει αναδείξει την επιρροή κορυφαίων ανθρώπων στον κόσμο της επιστήμης.
Συνεχίζοντας την παράδοση το 2023, φέτος αναγνωρίζεται επιπροσθέτως ο ρόλος της τεχνητής νοημοσύνης, που έχει σχεδιαστεί για να μιμείται την ανθρώπινη γλώσσα, στην ανάπτυξη και την πρόοδο της επιστήμης.
Οι 10 πιο επιδραστικοί επιστήμονες του Nature
Kalpana Kalahasti: Στο φεγγάρι
Ο μηχανικός και μάνατζερ έπαιξε καθοριστικό ρόλο στη διασφάλιση της θριαμβευτικής αποστολής του Chandrayaan-3 στη Σελήνη, καθιστώντας την Ινδία μόνο την τέταρτη χώρα που πέτυχε το κατόρθωμα.
Marina Silva: προστάτης του Αμαζονίου
Ο υπουργός Περιβάλλοντος της Βραζιλίας βοήθησε να περιοριστεί η αχαλίνωτη αποψίλωση των δασών και να ανοικοδομηθούν ιδρύματα που είχαν αποδυναμωθεί από την προηγούμενη κυβέρνηση.
Katsuhiko Hayashi: Επανακαλωδίωση αναπαραγωγής
Το κατόρθωμα του να δημιουργήσει βιώσιμα ωάρια από κύτταρα αρσενικών ποντικών θα μπορούσε να βοηθήσει στη διάσωση ειδών στο χείλος της εξαφάνισης.
Annie Kritcher: Fusion igniter
Αυτός ο φυσικός βοήθησε την Εθνική Εγκατάσταση Ανάφλεξης των ΗΠΑ να παράγει πυρηνικές αντιδράσεις που κάποτε μπορούσαν να παρατηρηθούν μόνο σε βόμβες υδρογόνου και αστέρια.
Ελένη Μυριβήλη: Θερμοφύλακας
Ως επικεφαλής των Ηνωμένων Εθνών για τη θερμότητα, η πρώην πολιτικός βοηθά τον κόσμο να προετοιμαστεί για τις απειλές της κλιματικής αλλαγής.
Ilya Sutskever: Οραματιστής AI
Πρωτοπόρος του ChatGPT και άλλων συστημάτων AI που αλλάζουν την κοινωνία.
James Hamlin: Πρωτοπόρος υπεραγωγιμότητας
Αυτός ο φυσικός βοήθησε να εντοπιστούν ελαττώματα στους εντυπωσιακούς ισχυρισμούς περί υπεραγωγιμότητας σε θερμοκρασία δωματίου.
Svetlana Mojsov: Αφανής προγραμματιστής φαρμάκων
Μια βιοχημικός κέρδισε τελικά την αναγνώριση για το ρόλο της στην ανάπτυξη φαρμάκων απώλειας βάρους, σε μια βιομηχανία πολλών δισεκατομμυρίων δολαρίων.
Halidou Tinto: Πολέμιος της ελονοσίας
Ένα δεύτερο εμβόλιο για μια θανατηφόρα μάστιγα θα κυκλοφορήσει σύντομα, χάρη στις αυστηρές δοκιμές αυτού του ερευνητή.
Thomas Powles: Εξερευνητής του καρκίνου
Αυτός ο γιατρός και ερευνητής καρκίνου οδήγησε μια μεταμορφωτική κλινική δοκιμή για τη θεραπεία του σοβαρού καρκίνου της ουροδόχου κύστης.
ΤΑ ΠΙΟ ΔΗΜΟΦΙΛΗ

ΔΙΑΒΑΖΟΝΤΑΙ ΠΑΝΤΑ
ΔΕΙΤΕ ΕΠΙΣΗΣ
Ερευνητές του Πανεπιστημίου του Κέιμπριτζ δημιούργησαν ένα «υπερ-αντιγόνο» ικανό να προστατεύσει από μελλοντικές πανδημίες
Η στροφή των χρηστών από τα κινητά στις τηλεοράσεις αλλάζει τις ισορροπίες στην παγκόσμια αγορά της ψυχαγωγίας
Οι εκτιμήσεις σοκ έκθεσης του ΟΗΕ
Το ΑΙ γράφει πια τα πάντα και τα γράφει με τη δική του, χαρακτηριστική φωνή – μόνο εμένα μου φαίνεται κάπως εκνευριστική;
Η Sydney Morning Herald απέσυρε το κείμενο της καθηγήτριας Κάθριν Έλις ως «απαράδεκτο»
H εταιρεία στοχεύει να διαθέτει έως το 2029 μια κβαντική μηχανή ικανή να επιλύει πραγματικά προβλήματα για επιχειρήσεις και βιομηχανίες
Η μητρική εταιρεία της Google προχωρά σε μία από τις μεγαλύτερες χρηματοδοτήσεις στην ιστορία
Ο Ελληνοολανδός γιατρός που προετοιμάζει τα χειρουργεία του διαστήματος
«Η Ευρώπη δεν έχει χάσει τη μάχη της AI, αλλά κινδυνεύει να αυτοϋπονομευθεί», λέει ο CEO του 28 DIGITAL
Βιολόγοι εξηγούν πώς η εξέλιξη και η ανατομία δημιούργησαν τη μοναδικότητα της ανθρώπινης φωνής
Η κλινική δοκιμή περιέλαβε περίπου 900 νεοδιαγνωσθέντες ασθενείς,
Η κλινική δοκιμή περιέλαβε περισσότερους από 4.400 ασθενείς
Νέα έρευνα δείχνει ότι οι επιχειρήσεις σχεδιάζουν μαζικές αλλαγές και λιγότερους εργαζόμενους
Ο 48χρονος προγραμματιστής και μουσικός με οπτική αναπηρία μιλά για τη ζωή σε μια αφιλόξενη Ελλάδα, την AI και τη μάχη να αντιμετωπίζεται ως άνθρωπος
Η πλατφόρμα δημιουργεί το Pornhub Sapphic, με περιεχόμενο εστιασμένο στη γυναικεία απόλαυση
Πρόκειται περί αληθινής αγγελίας – Τα προσόνα που πρέπει να έχουν οι ενδιαφερόμενοι
Βίντεο δείχνει τον πύραυλο να τυλίγεται στις φλόγες
Η Κίνα προχωρά στα δικά της σχέδια για την αποστολή ανθρώπων στη Σελήνη έως το 2030
Χρήστες εκφράζουν φόβους για τον ρόλο της τεχνητής νοημοσύνης στη μουσική
Έχετε δει 20 από 200 άρθρα.























































